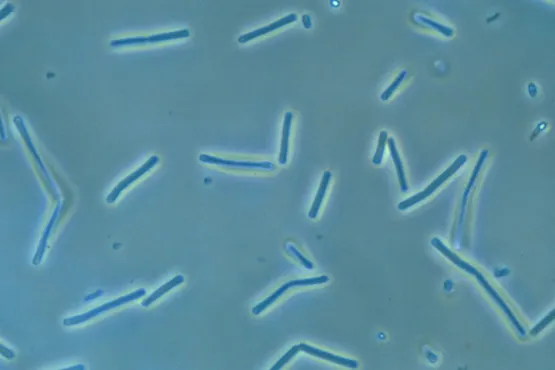

Полезные микроорганизмы в сельском хозяйстве, животноводстве и окружающей среде.
Микроорганизмы, принадлежащие компании Microbalance
1. Виды полезных микроорганизмов в сельском хозяйстве
사진 출처 : wikipedia
1. Bacillus megaterium
•
Сельскохозяйственные полезные активные свойства : Повышение плодородия почвы, фиксация азота
•
Сельскохозяйственное применение : Стимулятор роста растений, биологическое удобрение
•
Подробное описание : Bacillus megaterium обладает выдающейся способностью повышать плодородие почвы и улучшать баланс питательных веществ в почве посредством фиксации азота. Эти свойства помогают растениям расти, сокращают использование удобрений и способствуют снижению зависимости от химических удобрений. Кроме того, Bacillus megaterium укрепляет корневую систему растения и повышает его устойчивость к болезням. Эти микроорганизмы могут использоваться как часть экологически чистых сельскохозяйственных методик и играть важную роль в устойчивых методах ведения сельского хозяйства.
사진 출처 : wikipedia
2. Bacillus subtilis
•
Сельскохозяйственные полезные активные свойства : Подавляет патогены и повышает иммунитет растений
•
Сельскохозяйственное применение : Средство биологической борьбы, профилактика болезней растений
•
Подробное описание : Bacillus subtilis обладает способностью естественным образом ингибировать патогены растений, что делает ее очень эффективной в предотвращении болезней растений. Эти микроорганизмы активируют естественную иммунную систему растения, помогая растению самостоятельно бороться с болезнями. Агенты биологической борьбы на основе Bacillus subtilis считаются хорошей альтернативой химическим средствам борьбы, менее вредны для окружающей среды и позволяют применять устойчивые методы ведения сельского хозяйства. Эти микроорганизмы также имеют дополнительное преимущество: они способствуют здоровью почвы, помогая улучшить ее плодородие в долгосрочной перспективе.
사진 출처 : Science Photo Library
3. Bacillus amyloliquefaciens
•
Сельскохозяйственные полезные активные свойства : Улучшение почвы, подавление патогенов растений
•
Сельскохозяйственное применение : Биологический кондиционер почвы, средство борьбы с вредителями
•
Подробное описание : Bacillus amyloliquefaciens — микроорганизм с отличными способностями к улучшению почвы и подавлению патогенов растений. Эти микроорганизмы помогают улучшить структуру и плодородие почвы, способствуя разложению органических веществ в почве. Кроме того, он обладает естественной устойчивостью к некоторым патогенам растений и играет важную роль в защите растений от патогенов. Bacillus amyloliquefaciens — это средство биологической борьбы, которое способствует снижению небезопасного использования химических средств борьбы и принимается как часть экологически безопасной сельскохозяйственной практики.
사진 출처 : wikipedia
4. Bacillus thuringiensis
•
Сельскохозяйственные полезные активные свойства : борьба с вредителями
•
Сельскохозяйственное применение : биологический агент борьбы с вредителями
•
Подробное описание : Bacillus thuringiensis — микроорганизм, используемый в основном для борьбы с вредителями. Токсины, вырабатываемые этими микроорганизмами, воздействуют только на конкретных вредителей, что позволяет эффективно бороться с вредителями. Продукты на основе Bacillus thuringiensis менее вредны для окружающей среды, чем химические средства борьбы с вредителями, и безопасны для нецелевых организмов. Благодаря этим свойствам Bacillus thuringiensis широко используется в органическом сельском хозяйстве и играет важную роль в устойчивых методах ведения сельского хозяйства. Кроме того, эти микроорганизмы с меньшей вероятностью развивают устойчивость к вредителям, что делает их эффективным средством борьбы с вредителями при длительном использовании.
사진 출처 : https://www.chungvisinh.com/
5. Rhodobacter sphaeroides
•
Сельскохозяйственные полезные активные свойства : фотосинтез, фиксация азота
•
Сельскохозяйственное применение : Улучшение почв, регулирование баланса экосистем
•
Подробное описание : Rhodobacter sphaeroides производит органические вещества посредством фотосинтеза и повышает плодородие почвы благодаря своей способности фиксировать азот. Эти микроорганизмы играют важную роль в поддержании баланса почвенных экосистем и могут напрямую способствовать росту растений. Использование Rhodobacter sphaeroides способствует улучшению здоровья почвы и увеличению биоразнообразия. Кроме того, эти микроорганизмы могут действовать как натуральные удобрения, сокращая использование химических удобрений, и могут применяться в рамках экологически чистых методов ведения сельского хозяйства.
사진 출처 : Microbe Canvas
6. Streptomyces griseus
•
Сельскохозяйственные полезные активные свойства : Производство антибиотиков, ингибирование болезнетворных микроорганизмов
•
Сельскохозяйственное применение : Природный антибиотик, средство защиты растений
•
Подробное описание : Streptomyces griseus обладает способностью вырабатывать мощные антибиотики, эффективно подавляющие болезнетворные микроорганизмы растений. Использование этих микроорганизмов играет важную роль в защите растений от различных патогенов и позволяет сократить использование химических пестицидов. Природные антибиотики Streptomyces griseus подходят для органического земледелия и обеспечивают защиту растений с минимальным негативным воздействием на окружающую среду. Эти микроорганизмы также способствуют здоровью почвы и способствуют биологическому разнообразию.
사진 출처 : wikipedia
7. Saccharomyces cerevisiae
•
Сельскохозяйственные полезные активные свойства : Стимулирует ферментацию и рост
•
Сельскохозяйственное применение : Стимулятор роста растений, стимулятор ферментации
•
Подробное описание : Saccharomyces cerevisiae — это дрожжи, широко используемые в процессах ферментации, а также играющие различные роли в сельском хозяйстве. Эти микроорганизмы ускоряют разложение органических веществ в почве, тем самым повышая доступность питательных веществ для растений. Использование Saccharomyces cerevisiae может улучшить здоровье корней растений и способствовать общему росту. Кроме того, эти дрожжи оказывают низкое воздействие на окружающую среду и считаются природным ресурсом, подходящим для устойчивого ведения сельского хозяйства.
8. Burkholderia cepacia
•
Сельскохозяйственные полезные активные свойства : Подавляет патогены и способствует росту растений
•
Сельскохозяйственное применение : Агент биологического контроля, стимулятор роста
•
Подробное описание : Burkholderia cepacia обладает способностью подавлять патогены растений и стимулировать рост растений. Эти микробы способствуют развитию полезных микробных сообществ в почве, тем самым улучшая ее здоровье. Использование Burkholderia cepacia снижает зависимость от химических пестицидов и обеспечивает менее вредную для окружающей среды альтернативу. Кроме того, эти микроорганизмы способствуют укреплению корневой системы растения и улучшению общего состояния растения.
사진 출처 : wikipedia
9. Burkholderia pyrrocinia
•
Сельскохозяйственные полезные активные свойства : Антибактериальные и противогрибковые свойства
•
Сельскохозяйственное применение : агент биологической борьбы
•
Подробное описание : Буркхолдерия пирроциния обладает сильными антибактериальными и противогрибковыми свойствами, что позволяет эффективно бороться с патогенами растений. Эти микроорганизмы могут защитить здоровье растений и снизить потери от болезней. Буркхолдерия пирроциния является средством биологической борьбы с низкой нагрузкой на окружающую среду и считается хорошей альтернативой химическим средствам борьбы. Кроме того, эти микроорганизмы играют важную роль в поддержании биоразнообразия почвы и поддерживают устойчивые методы ведения сельского хозяйства.
사진 출처 : BacDive
10. Pseudomonas chlororaphis
•
Сельскохозяйственные полезные активные свойства : Подавляет патогены и способствует росту
•
Сельскохозяйственное применение : Средство биологической борьбы, средство защиты растений
•
Подробное описание : Pseudomonas chromraphis обладает способностью эффективно подавлять патогены растений и стимулировать рост растений. Эти микроорганизмы укрепляют иммунитет растения и повышают его устойчивость к болезням. Pseudomonas chromraphis оказывает низкое воздействие на окружающую среду и может использоваться в качестве альтернативы химическим пестицидам. Использование этих микроорганизмов поддерживает здоровье почвы и способствует устойчивым методам ведения сельского хозяйства.
사진 출처 : microbiologyresearch
11. Pseudomonas frederiksbergensis
•
Сельскохозяйственные полезные активные свойства : Удаление тяжелых металлов, улучшение почвы
•
Сельскохозяйственное применение : Восстановление окружающей среды, биоремедиация
•
Подробное описание : Pseudomonas frederiksbergensis обладает прекрасной способностью удалять из почвы тяжелые металлы, способствуя тем самым восстановлению загрязненной почвы. Эти микроорганизмы способны снижать концентрацию тяжелых металлов в почве, уменьшая их вредное воздействие на растения и окружающую экосистему. Кроме того, Pseudomonas frederiksbergensis улучшает структуру почвы и ускоряет разложение органических веществ, тем самым повышая плодородие и здоровье почвы. Эти микроорганизмы играют важную роль в проектах по восстановлению окружающей среды и биоремедиации и могут способствовать устойчивому сельскому хозяйству и управлению окружающей средой.
12. Beauveria bassiana
•
Сельскохозяйственные полезные активные свойства : борьба с вредителями
•
Сельскохозяйственное применение : биологический агент борьбы с вредителями
•
Подробное описание : Beauveria bassiana — эффективный грибок для борьбы с вредителями, который заражает определенных вредителей и уничтожает их изнутри. Этот гриб используется как естественный способ отпугивания вредителей и считается экологически чистой альтернативой химическим средствам борьбы с вредителями. Использование Beauveria bassiana может уменьшить повреждение урожая вредителями и повысить продуктивность сельского хозяйства. Кроме того, этот гриб оказывает низкую нагрузку на окружающую среду, что делает его пригодным для устойчивых методов ведения сельского хозяйства. Beauveria bassiana играет важную роль в биологической борьбе с вредителями и широко используется в органическом сельском хозяйстве и экологически безопасных методах ведения сельского хозяйства.
2. Виды полезных микроорганизмов в животноводстве
사진 출처 : wkitionary
1. Lactobacillus acidophilus
•
Полезные активные свойства скота : Поддерживает микробный баланс кишечника и повышает иммунитет
•
Использование в животноводстве : Кормовая добавка, способствует здоровью животных
•
Подробное описание : Lactobacillus acidophilus – пробиотический микроорганизм, улучшающий кишечную среду скота и способствующий росту полезных микроорганизмов. Эти микроорганизмы укрепляют иммунную систему домашнего скота и улучшают общее состояние здоровья, подавляя рост вредных бактерий в кишечнике. Добавляя в корм Lactobacillus acidophilus, домашний скот может улучшить усвоение и переваривание питательных веществ, а также повысить устойчивость к болезням. Благодаря этим свойствам Lactobacillus acidophilus способствует улучшению здоровья животных и повышению продуктивности в животноводстве. Кроме того, использование этих микроорганизмов играет важную роль в сокращении использования антибиотиков и продвижении устойчивых методов животноводства.
사진 출처 : microbewiki
2. Lactobacillus plantarum
•
Полезные активные свойства скота : Улучшает эффективность пищеварения, повышает иммунитет
•
Использование в животноводстве : Кормовая добавка, укрепление здоровья
•
Подробное описание : Lactobacillus plantarum – пробиотик, который поддерживает микробный баланс кишечника у сельскохозяйственных животных и улучшает процесс пищеварения. Эти микроорганизмы повышают способность скота усваивать питательные вещества и улучшают здоровье кишечника, тем самым улучшая общее состояние здоровья и темпы роста. Использование Lactobacillus plantarum помогает животноводству усваивать больше питательных веществ из корма, способствуя повышению продуктивности. Кроме того, эти микроорганизмы помогают поддерживать здоровье скота, укрепляя иммунную систему и повышая устойчивость к болезням. Lactobacillus plantarum используется для поддержания здоровья и профилактики заболеваний в животноводстве.
사진 출처 : NOVACO
3. Lactobacillus casei
•
Полезные активные свойства скота : Улучшает здоровье кишечника, укрепляет иммунную систему
•
Использование в животноводстве : Кормовая добавка, укрепление здоровья
•
Подробное описание : Lactobacillus casei – пробиотический микроорганизм, улучшающий кишечную среду скота и способствующий росту полезных микроорганизмов. Эти микроорганизмы укрепляют пищеварительную систему скота, усиливают всасывание питательных веществ, подавляют активность вредных кишечных бактерий. Использование Lactobacillus casei способствует повышению иммунитета скота и защите его от различных заболеваний. Эти микроорганизмы играют важную роль в поддержании здоровья животных и повышении продуктивности в животноводстве. Lactobacillus casei — это естественный способ сократить чрезмерное использование антибиотиков и поддержать устойчивые методы животноводства.
출처 확인 필요(논문 figure)
4. Pichia farinosa
•
Полезные активные свойства скота : Уменьшает запах, способствует ферментации корма, подавляет патогены
•
Использование в животноводстве : Улучшенный корм, улучшенное здоровье
•
Подробное описание : Pichia Farinosa оказывает прямое влияние на уменьшение запаха скота и часто используется для контроля окружающей среды в животноводстве. Кроме того, дрожжи используются в процессе ферментации кормов. Эти микроорганизмы играют роль в повышении питательной ценности кормов и подавлении роста вредных бактерий в кормах. Ферментированные корма с использованием Pichia Farinosa улучшают пищеварительную способность скота и укрепляют здоровье. Эти микроорганизмы помогают регулировать кишечную среду и укреплять иммунную систему скота. Это дополнительно повышает эффективность потребления корма и косвенно уменьшает запах скота. Кроме того, использование Pichia Farinosa повышает безопасность кормов и позволяет скоту лучше реагировать на болезни. Использование этих микроорганизмов в животноводстве играет важную роль в улучшении качества кормов и поддержании общего состояния здоровья и благополучия скота.
사진 출처 : Fido Pharma 출처 확인 필요
5. Clostridium butyricum
•
Полезные активные свойства скота : Улучшение кишечной среды, подавление болезнетворных микроорганизмов
•
Использование в животноводстве : Пробиотическая кормовая добавка, укрепляющая здоровье
•
Подробное описание : Clostridium Butyricum — пробиотический микроорганизм, который улучшает кишечную среду домашнего скота и способствует росту полезных микроорганизмов. Эти микроорганизмы подавляют активность вредных бактерий в кишечнике, способствуют здоровью кишечника и улучшают всасывание питательных веществ. Clostridium Butyricum укрепляет иммунную систему скота и помогает защитить его от различных заболеваний. Использование этих микроорганизмов играет важную роль в поддержании здоровья скота и повышении продуктивности в животноводстве. Clostridium Butyricum считается естественным способом сокращения использования антибиотиков и поддержки устойчивых методов животноводства.
3. Виды полезных микроорганизмов в окружающей среде
출처 확인 필요(논문 figure)
1. Bacillus siamensis
•
Экологические полезные активные свойства : Биоразлагаемость, азотный цикл, подавление патогенов
•
Экологические приложения : Улучшение почв, биологический контроль, восстановление окружающей среды
•
Подробное описание : Bacillus siamensis обладает способностью разлагать различные органические соединения, способствуя биоразложению почвы и загрязнителей окружающей среды. Эти микроорганизмы обладают активностью круговорота азота в почве, поддерживают рост растений и улучшают окружающую среду при избытке азота. Кроме того, Bacillus siamensis обладает способностью подавлять патогены в почве, поэтому ее можно использовать для биологического контроля. Благодаря этим характеристикам Bacillus siamensis играет важную роль в проектах восстановления окружающей среды и устойчивых методах ведения сельского хозяйства. Эти микроорганизмы способствуют сокращению использования химических удобрений и пестицидов и считаются экологически чистой альтернативой с минимальным негативным воздействием на окружающую среду.
출처 확인 필요(논문 figure)
2. Bacillus Bacillus tequilensis
•
Экологические полезные активные свойства : Разложение органических веществ, ингибирование болезнетворных микроорганизмов, биоремедиация
•
Экологические приложения : Улучшение почв, биологический контроль, восстановление окружающей среды
•
Подробное описание : Bacillus siamensis обладает способностью разлагать различные органические соединения, способствуя биоразложению почвы и загрязнителей окружающей среды. Эти микроорганизмы обладают активностью круговорота азота в почве, поддерживают рост растений и улучшают окружающую среду при избытке азота. Кроме того, Bacillus siamensis обладает способностью подавлять патогены в почве, поэтому ее можно использовать для биологического контроля. Благодаря этим характеристикам Bacillus siamensis играет важную роль в проектах восстановления окружающей среды и устойчивых методах ведения сельского хозяйства. Эти микроорганизмы способствуют сокращению использования химических удобрений и пестицидов и считаются экологически чистой альтернативой с минимальным негативным воздействием на окружающую среду.